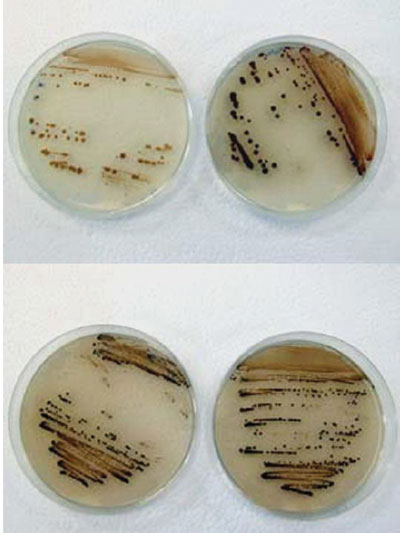

| 2006 |

|
YEAR BOOK |
University College Dublin
|
Tanned bugs may hold the key to new drugs!
|
The substrates involved in this study are substituted phenols, some of which are fluorinated compounds known to be xenobiotic substances. These are important environmental pollutants arising mainly from human activities. Many of the reactions catalysed by tyrosinase result in a coloured product thus allowing for visible detection, for example, hair colour, skin colour, browning of bananas.
Tyrosinase is present in microbial cells for protection against UV light in the same way as it is present in mammalian melanocytes for protection against sunlight. The activity of tyrosinase is the basis for many industrial applications such as biosensors for the monitoring of phenols; in the pharmaceutical industry for the production of o-diphenols such as L-DOPA, which is used for the treatment of Parkinson's disease; in the cosmetic and food industries due to the undesirable or beneficial browning reactions.
The focus of my project involves looking further at the structure and function of tyrosinase in microbial cells and altering the enzyme by genetic manipulation to improve its efficiency for practical application.
*Leona Martin, Conway Synthesis and Chemical Biology, won Second Place in AccessScience 'O6; a competition for 3rd year post-graduates held in UCD in March 'O6. This is a summary of her presentation.
Contact: Leona Martin
UCD School of Biomolecular & Biomedical Science, UCD Conway Institute and CSCB,
University College Dublin, Belfield, Dublin 4.
T: (+353-1) 716 1309
E-mail: [email protected]